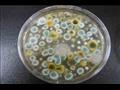

الفطريات السوداء والبيضاء والصفراء.. 4 أساطير شائعة حول العدوى
كتبت- هند خليفة
-
عرض 5 صورة
-
عرض 5 صورة

-
عرض 5 صورة

-
عرض 5 صورة

-
عرض 5 صورة

أصيب شعوب العالم بحالة من الذعر عقب كثرة الأقاويل عن انتشار مرض الفطر الأسود بين المتعافين من كورونا وخروجه من دولة الهند، وأصاب هذا الذعر أيضًا المصريين بعد ما كشفت وزارة الصحة المصرية عن رصد حالات من مرض الفطر الأسود.
وقد أدى ذلك أيضًا إلى الكثير من المفاهيم الخاطئة حول العدوى الجديدة، مما زاد الأمر سوءًا، وفي هذا الإطار استعرض موقع timesofindia بعض الخرافات الشائعة المتعلقة بجميع أنواع الالتهابات الفطرية.
-ما هي العدوى الفطرية؟
أسود أو أبيض أو أصفر، جميع أنواع العدوى الفطرية ناتجة عن العفن أو الفطريات الموجودة بالفعل في البيئة، ولا تسبب هذه القوالب أي نوع من العدوى في الشخص السليم، ومع ذلك، عندما يتنفس شخص يعاني من ضعف المناعة أو يعاني من أي حالة صحية كامنة الجراثيم، فإنه يصاب بعدوى، لتشمل أعراضها الحمى وآفة الجلد وضيق التنفس والصداع والتعب، ويمكن علاج الحالة بالأدوية إذا تم اكتشافها مبكرًا، وإلا يتعين على المرء الخضوع لعملية جراحية لإزالة الجزء المصاب.
-هل العدوى الفطرية معدية؟
العدوى الفطرية ليست معدية مما يعني أنه لا يمكن نقلها إلى شخص سليم بعد الاتصال الوثيق بشخص مصاب، فعادة ما تكون القوالب موجودة في البيئة ونتنفسها جميعًا، ويصاب بالعدوى فقط لاأشخاص الذين يعانون من ضعف المناعة بسبب الاستخدام المفرط للستيرويدات ومرض السكري غير المنضبط، كما يرتبط تناول الزنك ومزيج من المضادات الحيوية المستخدمة لعلاج فيروس كورونا أيضًا بتفشي الحالات الفطرية.
-هل فقط الأشخاص الذين يعانون من COVID-19 يصابون بهذه العدوى؟
من الصعب تجنب العفن الذي يسبب هذه الالتهابات الفطرية لأنها موجودة في كل مكان حولنا، خاصة في التربة وفي المواد العضوية المتحللة، مثل الأوراق أو أكوام السماد أو الخشب الفاسد، فيمكن أن يسبب العدوى لأي شخص لديه جهاز مناعة ضعيف، أولئك الذين يعانون من مرض السكري وفيروس نقص المناعة البشرية معرضون أيضًا للخطر.
-هل العدوى الفطرية البيضاء أخطر من العدوى الفطرية السوداء؟
تشير العديد من التقارير إلى أن العدوى الفطرية البيضاء أكثر خطورة من العدوى السوداء، ومع ذلك، هذا ليس صحيحا، فالفطريات البيضاء خطيرة مثل الفطر الأسود.
ووفقًا لبعض الخبراء فإن العدوى الفطرية البيضاء التي يتم الإبلاغ عنها ليست سوى داء المبيضات، وقد شدد البعض في الواقع على أن التهاب الغشاء المخاطي أو العدوى الفطرية السوداء أكثر تغلغلًا وقد تسبب الكثير من الضرر للجيوب الأنفية والعينين والدماغ وتتطلب جراحة مكثفة.







































